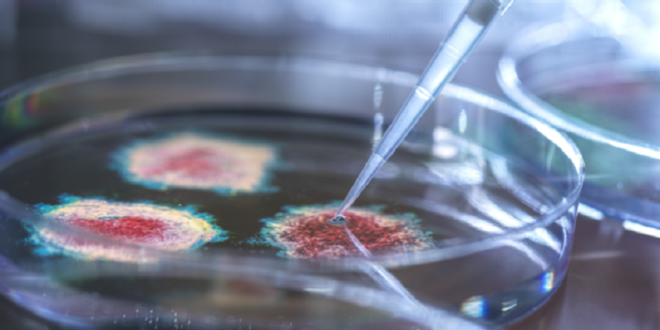

منبر العراق الحر : طور علماء من جامعة ستانفورد لقاحا واعدا يمكن أن يوفر حماية شاملة ضد نزلات البرد والإنفلونزا و”كوفيد-19″ والحساسية، في خطوة قد تمثل نقلة نوعية في الوقاية من التهابات الجهاز التنفسي.
واختبر العلماء تركيبة اللقاح على الفئران، حيث أثبتت فعاليتها ضد مجموعة متنوعة من الفيروسات التنفسية، والبكتيريا المسببة لتسمم الدم، وحتى عث الغبار المنزلي. ويُعطى اللقاح عن طريق رذاذ أنفي، ويمنح حماية طويلة الأمد للرئتين تمتد لعدة أشهر.
وقال الدكتور بالي بوليندران، مدير معهد المناعة وزراعة الأعضاء والعدوى في كلية الطب بجامعة ستانفورد والمعد الرئيسي للدراسة: “أعتقد أننا توصلنا إلى لقاح شامل ضد مختلف التهديدات التنفسية. تخيلوا الحصول على رذاذ أنفي في فصل الخريف يحميكم من جميع الفيروسات التنفسية، بما في ذلك “كوفيد-19″ والإنفلونزا والفيروس المخلوي التنفسي ونزلات البرد، إضافة إلى الالتهاب الرئوي البكتيري ومسببات الحساسية في أوائل الربيع. سيُحدث ذلك نقلة نوعية في الممارسة الطبية”.
وفي الدراسة، أُعطيت الفئران قطرة من اللقاح المعروف باسم GLA-3M-052-LS+OVA في أنوفها، ما وفر لها حماية لعدة أشهر. وأظهرت التجارب أن الخلايا التائية المساعدة في الرئتين، المسؤولة عن مكافحة مسببات الأمراض، قادرة على إرسال إشارات إلى خلايا المناعة الفطرية للحفاظ على نشاطها. وبدلا من محاكاة جزء من مسبب المرض، يحاكي اللقاح الإشارات التي تستخدمها خلايا المناعة للتواصل أثناء العدوى.
ويعتقد بوليندران أن جرعتين من رذاذ الأنف قد تكفيان لتوفير الحماية للبشر، ويقدّر أن اللقاح قد يصبح متاحا خلال خمس إلى سبع سنوات، اعتمادا على التمويل.
ووصفت دانييلا فيريرا، أستاذة علم اللقاحات في جامعة أكسفورد، الدراسة بأنها “مثيرة”، موضحة: “نتعرض باستمرار طوال حياتنا للفيروسات والبكتيريا التي تصيب الجهاز التنفسي، ونتيجة لذلك، يحمل معظمنا خلايا مناعية ذاكرة، بما في ذلك بعض الخلايا التي تعيش في بطانة الأنف والرئتين. وتظهر هذه الدراسة أنه قد يكون من الممكن استخدام ذاكرة المناعة الموجودة كأساس لحماية واسعة النطاق، حتى من مسببات الأمراض غير ذات الصلة”.
ومن جهة أخرى، حذر بعض الخبراء من أن الوصول إلى لقاح شامل يظل تحديا بعيد المنال. فقال البروفيسور إيان جونز، عالم الفيروسات في جامعة ريدينغ: “ما زلنا بعيدين عن لقاح يُعطى بجرعة واحدة فقط، إذ أن اعتبارات السلامة بالغة الأهمية نظرا لتنوع البشر. قد لا يكون لقاح واحد فعالا للجميع، وستبقى اللقاحات الموسمية الحالية هي السائدة لبعض الوقت”.
كما أشار البروفيسور جوناثان بول، عالم الفيروسات في كلية ليفربول للطب الاستوائي، إلى أن العلماء أحرزوا “خطوات كبيرة” نحو لقاح شامل، محذرا من أن إبقاء الجسم في حالة تأهب قصوى قد يؤدي إلى آثار جانبية غير مرغوبة.
نشرت الدراسة في مجلة Science.
المصدر: إندبندنت
 منبر العراق الحر منبر العراق الحر
منبر العراق الحر منبر العراق الحر